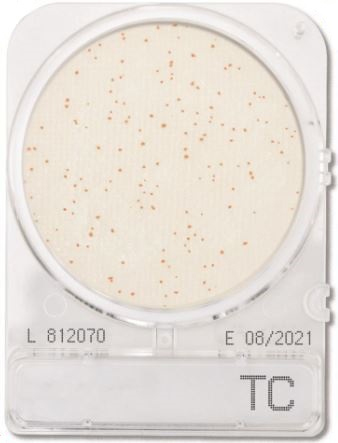
Đĩa Compact Dry

Giá:
Xuất xứ: NISSUI - NHẬT BẢN
Kích thước 4đĩa/ Gói
Đĩa Compact Dry kiểm tra tổng khuẩn hiếu khí | Total Viable Count TC | Nissui
Hãng sản xuất: Nissui – Nhật Bản
Quy cách đóng gói: 4 đĩa/gói
Nhiệt độ ủ: 35 ± 2°C
Thời gian ủ: 48 ± 3 giờ
Màu sắc khuẩn lạc: all colonies.
Sản phẩm được chứng nhận của các tổ chức AOAC, MicroVal, NordVal
- Đề cập đến tất cả các vi sinh vật có trong một mẫu có thể chịu được sự hiện diện của oxy và không có các yêu cầu tăng trưởng cụ thể thường không được bao gồm trong các công thức của môi trường. Theo quy định của cơ quan quản lý thực phẩm và dược phẩm (FDA), tổng khuẩn hiếu khí được coi là một trong những thông số điển hình và tiêu biêu cho thực phẩm (thực phẩm đông lạnh, ướp lạnh, sơ chế và chế biến sẵn), mẫu dược phẩm.
- Vì lẽ đó, quy trình kiểm nghiệm tổng khuẩn hiếu khí được khuyến nghị, và đĩa Compact Dry Total Viable Count mang đến sự tiện lợi cho người sử dụng bởi ưu điểm không cần chuẩn bị hóa chất môi trường, dụng cụ, vật tư tiêu hao phức tạp. Tất cả công nghệ được sử dụng cho đĩa Compact Dry Total Viable Count này là môi trường được đổ sẵn. Và người sử dụng chỉ cần trích ly mẫu, nhỏ mẫu vào đĩa và đem đi ủ.
* Ứng dụng trên các mẫu:
- Mẫu lỏng: Nước thải, nước sinh hoạt…
- Mẫu rắn: Thức ăn chăn nuôi, sữa, sữa bột, thịt, cá, tôm…
- Quy trình đơn giản dễ sử dụng, không cần chuẩn bị vật tư tiêu hao hay thiết bị phức tạp.
- Dễ dàng sử dụng và không mất thời gian đào tạo người sử dụng.
- Đĩa compact dry có thể bảo quản dễ dàng nhờ quy cách đóng gói 4 đĩa 1 gói.
- Kết quả khá chính xác, dễ phân tích và có kết quả sau 48 giờ.
- Có thể tách lấy khuẩn lạc để test sinh hóa.
- Cân vô trùng 10,0g mẫu hoặc dùng pippette lấy 10,0ml (đối với mẫu là dung dịch) cho vào dụng cụ vô trùng thích hợp (ví dụ như túi tiệt trùng đựng mẫu, chai pha loãng, túi Whirl Park).
- Thêm 90,0ml chất pha loãng để đạt được độ pha loãng 1:10 và đem đi đồng nhất mẫu. Điều chỉnh pH nếu cần thiết. Chất pha loãng được đề xuất thông thường là dung dịch đệm phosphate của Butterfield, chất pha loãng phục hồi tối đa và các chất pha loãng thích hợp khác tùy thuộc vào BAM.
- Nếu cần, có thể pha loãng mẫu hơn nữa.
- Mở nắp đĩa Compact Dry. Lấy 1,0ml mẫu pha loãng bằng micropipette, cho vào giữa đĩa Compact Dry. Đóng nắp đĩa lại.

- Đảo ngược và ủ đĩa compact dry ở điều kiện ủ cụ thể (Theo tiêu chuẩn AOAC International: 35 ± 2°C cho 48 ± 3 giờ, theo tiêu chuẩn Microval và NordVal: 30 ± 1°C cho 48 ± 3 giờ )
- Đọc kết quả
Mọi thông tin chi tiết vui lòng liên hệ
CÔNG TY TNHH GIẢI PHÁP CÔNG NGHỆ GIA LONG
Địa chỉ: 129/43/14/1 Liên Khu 5-6, Phường Bình Tân, Thành phố Hồ Chí Minh, Việt Nam
Hotline: 038.999.3000
Email: info@gialonglab.com
Website: gialonglab.com